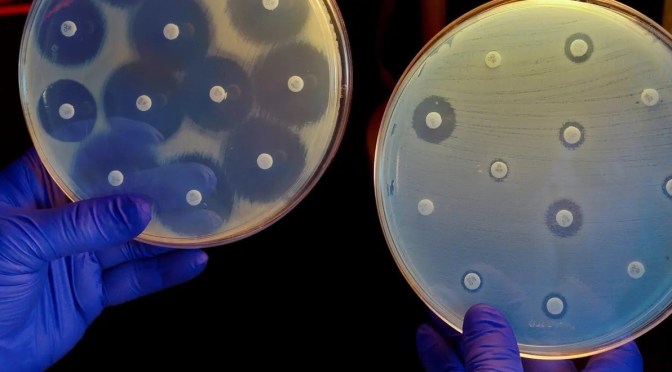
Dr. C’s Journal: The Rise Of Antimicrobial Resistance

A weekly podcast on the latest medical, science and telehealth news.
Monthly Archives: July 2022
Dr. C’s Journal: MRSA- Methicillin Resistant Staphylococcus Aureus
Staphylococcus aureus is a highly successful – eg.BAD – disease producing bacterium, or “pathogen”. From the standpoint of the bacterium, it didn’t know it was so bad, and was merely producing factors that break down its surroundings to produce food for multiplication. Unfortunately, the proteins-ENZYMES- produced by the staphylococcus, In its effort to survive, can cause anything from diarrhea, abscesses, high fevers, shock, and kidney failure to death.

The staphylococcus was very successful for thousands of years, until slowed down by penicillin.
Penicillin attached itself to a critical part of the staphylococcal cell wall, which stopped the bacterium from functioning. The staphylococcus retaliated by producing an enzyme, penicillinase, that destroys penicillin. Humans responded by producing methicillin, which resisted destruction by the penicillinase. The Staph responded again by a genetic change in the target of penicillin, PBP, so that the Methicillin wouldn’t attach, hence the term methicillin resistant staphylococcus aureus, MRSA.
Interestingly, the MRSA can send little packets of genes called “plasmids” to other bacteria, even other species, which take in the packets and allow them to resist methecillin also. This is called horizontal transfer of resistance.
The staphylococcus aureus has many other ways of protecting itself, and is a good example of the various ways a bacterium can deal with antibiotics.
It can prevent the antibiotic from gaining entrance, or pump it out of the cell faster. It can destroy the antibiotic, as with penicillinase. It can modify the bacterial target of the antibiotic, as in the PBP that protects from penicillin. It can also develop an alternative metabolic pathway or structure to bypass the effect of the antibiotic.
THIS IS WAR, similar to the human kind. The offense develops the sword. The defense develops the shield. The offense develops mounted archery. The defense develops the castle and so on.
We’re not so very different from the bacteria, and in fact every single cell of our bodies has descended from an ancestral bacterial cell that engulfed another bacterium, which became the mitochondrion, a “slave cell” dedicated to producing thousands of times more energy than the simple bacterium, and leading to multicellular organisms.
Each organism develops appropriate defenses. Penicillium molds developed penicillin to protect themselves from bacteria and we took advantage of this. But it is a dynamic process, with both offense and defense having to adapt repeatedly over time.
In the next article, I will be discussing the bacterium Pseudomonas aeruginosa which is not as dynamic as the staph aureus; It specializes in people with problems, and is called a “facultative pathogen”.
However Pseudomonas is particularly good at exploiting its specialized habitat, which is increasing with the popularity of immunosuppressants and insertion of surgical hardware.
—Dr. C.
Dr. C’s Journal: The Rise Of Antimicrobial Resistance
We are immersed in a vast sea of tiny organisms, microbes, most of which are either helpful or neutral. There are a few bad actors that can harm people and are responsible for plagues of the past, such as the black death, cholera and influenza epidemics.

This whole picture changed in the late 30s with the advent of Sulfonamides, and especially Penicillin, the “magic bullet”. I was practicing medicine early in the days when antibiotics eliminated almost all infections.
In fact, at one time infections were thought to be a problem of the past. Unfortunately, overusage, chronic multiple infections, surgically implanted devices, immune suppression for cancer and autoimmune diseases have allowed bacteria, fungi and viruses to evolve resistance mechanisms.
At the present time there are a number of bacteria, such as staphylococci, actino bacteria, enterococci, and candida that are essentially untreatable. Even if they are somewhat treatable, second and third level antibiotics are so toxic that they can cause problems with the kidney, liver, or heart.
In later postings, I plan to consider specific organisms and the situations in which they operate. I will also eventually talk about efforts to create new antibiotics by harvesting genetic material from unusual places, even our oceans.
—Dr. C.
Telemedicine: New Survey Finds Virtual Care Is Now Mainstream Care Delivery
“Telemedicine is here to stay,” said Dr. Rahul Sharma, professor and chair of emergency medicine at Weill Cornell Medicine and co-author of a commentary on the results. “Health care organizations really need to think about the next steps regarding the future of virtual care, such as how we integrate it into our systems, and how to make sure we are meeting the needs of both our clinicians and our patients.”

The survey, conducted in March, polled members of NEJM’s Catalyst Insight Council who are clinicians, clinical leaders and executives in organizations that deliver care. The survey received 984 responses from around the world, 609 from the United States. Dr. Sharma, who is also emergency physician-in-chief at New York-Presbyterian/Weill Cornell Medical Center and executive director of the Center for Virtual Care at Weill Cornell Medicine, helped formulate the questions with his co-author Dr. Judd E. Hollander, senior vice president of health care delivery innovation at Sidney Kimmel Medical College at Thomas Jefferson University in Philadelphia.
Of U.S. respondents, 71 percent reported that telemedicine has improved patient health, while a similar proportion said it provides at least moderate quality specialty or mental health care. For primary care, that share was 81 percent. When responses across all countries are included, the results differ only slightly from those of U.S. respondents.
Dr. C’s Journal: Signs & Symptoms Of Prostatitis
Prostatitis seems to be a catchall diagnosis varying anywhere from clear cut acute bacterial infection of the prostate gland with burning on urination, fever, positive cultures, and response to antibiotics, through recurrent nagging symptoms that can include pain on urination, urine flow obstruction, sexual dysfunction, blood in the urine, and chronic pain syndromes affecting the pelvic region.

Prostatitis constitutes perhaps 10% of urology practice, and is often frustrating to patients and physicians alike.
Symptoms are shared with BPH and prostate cancer, which are more clear-cut entities with standard diagnosis and treatment.
Prostate and bladder stones can give similar symptoms on rare occasions. STDs can be a diagnostic consideration in people with multiple sexual partners, and with international travel, we mustn’t forget parasitic infections.
From the patient’s standpoint, the important thing is to find a good urologist who can sort out the symptoms and find a proper diagnosis and treatment plan.
Please refer to the following Cleveland clinic article for a more orderly discussion.
—Dr. C.
Medicine: The ABCs Of Hepatitis (Mayo Clinic)
Approximately 5.3 million people in the US have hepatitis. Listen as Dr. Stacey Rizza breaks down the ABCs of hepatitis. Vaccines protect against hepatitis A, and are especially important for children and travelers. Hepatitis C is transmitted from person to person through bodily fluids. The virus can cause liver damage and death.
COMMENTS:
For the past three months, hundreds of cases of severe hepatitis cases among children have been noticed, especially in England and America, but present in more than 50 countries. These cases of Hepatitis were not caused by any of the usual suspects.
This puzzling increase in pediatric hepatitis apparently is due to Adenovirus 41, plus infection with adeno-associated virus 2. The double requirement is probably why it took a while to crack the causation mechanism. Genetic factors and the Covid lockdown may also have contributed.
—Dr. C.
Mayo Clinic: Bladder Cancer Explained
Learning about bladder cancer can be intimidating. Mark Tyson, M.D., a urologist at Mayo Clinic, walks you through the facts, the questions, and the answers to help you better understand this condition.
Video timeline: 0:00 Introduction 0:37 What is bladder cancer? 0:53 Who gets bladder cancer? / Risk factors 1:32 Symptoms of bladder cancer 1:59 How is bladder cancer diagnosed? 2:39 Treatment options 3:25 Coping methods/ What now? 4:04 Ending
For more reading visit: https://mayocl.in/3vcSF5u.
DOCTORS PODCAST: MEDICAL & TELEHEALTH NEWS (JULY 24)
A weekly podcast on the latest medical, science and telehealth news.
Infographics: Chronic Wounds In Older Adults

- •Chronic wounds are common, costly, and are more likely to affect older adults.
- •Venous ulcers, neuropathic ulcers, ischemic ulcers, and pressure injuries each necessitate unique prevention and treatment strategies.
- •With the evidence and pragmatic guidance provided herein, providers will have the working knowledge to successfully manage chronic wounds.
Appropriate prevention, diagnosis, and treatment of chronic wounds is important for providers across specialties. Wounds affect patients in all care settings and result in significant cost and morbidity. The burden of this condition falls largely on older adults, for whom the incidence of chronic wounds far exceeds that of younger populations.
Medicare costs for wound care in 2014 were estimated at greater than $28 billion, and the prevalence for most wound types was greatest in patients aged 75 or older.
Venous ulcers are the most common lower extremity wound type, comprising 45% to 60% of all wounds, followed by neuropathic ulcers (15% to 25%), ischemic ulcers (10% to 20%), and mixed ulcers (10% to 15%).
Fortunately, new wound-treatment modalities continue to emerge. This review summarizes the latest information regarding prevention, identification, classification, and treatment of chronic wounds. Guidance on management of major wound types and pearls regarding dressing selection are provided.
Low Back Pain: Top New Approaches To Treatment
How big is this problem, and what did this study find?
Worldwide, low back pain is a leading cause of disability and affects more than 560 million people. In the US, four in 10 people surveyed in 2019 had experienced low back pain within the past three months, according to the Centers for Disease Control and Prevention.
Protect yourself from the damage of chronic inflammation.
Science has proven that chronic, low-grade inflammation can turn into a silent killer that contributes to cardiovascular disease, cancer, type 2 diabetes and other conditions. Get simple tips to fight inflammation and stay healthy — from Harvard Medical School experts.